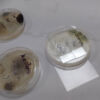
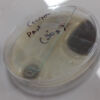

Feria de Ciencias STEX 2023 “Louis Pasteur” / Foire de Sciences STEX 2023 “Louis Pasteur”
 El día viernes 25 de agosto celebramos la fiesta de la ciencia en nuestro colegio, los alumnos de inicial, primaria y secundaria participaron en este evento científico, muchos de ellos demostraron sus habilidades y conocimientos a través de sus proyectos. Nuestra feria de ciencias lleva como nombre Louis Pasteur por el reconocimiento de sus logros científicos a través del tiempo se le atribuye la creación de la técnica conocida como pasteurización. Con sus teorías microbianas condujo al desarrollo de vacunas, antibióticos, la esterilización y la higiene, como métodos efectivos de cura y prevención contra la propagación de las enfermedades infecciosas, es por eso que nuestro colegio marca su relevancia e importancia en los aportes a la humanidad.
El día viernes 25 de agosto celebramos la fiesta de la ciencia en nuestro colegio, los alumnos de inicial, primaria y secundaria participaron en este evento científico, muchos de ellos demostraron sus habilidades y conocimientos a través de sus proyectos. Nuestra feria de ciencias lleva como nombre Louis Pasteur por el reconocimiento de sus logros científicos a través del tiempo se le atribuye la creación de la técnica conocida como pasteurización. Con sus teorías microbianas condujo al desarrollo de vacunas, antibióticos, la esterilización y la higiene, como métodos efectivos de cura y prevención contra la propagación de las enfermedades infecciosas, es por eso que nuestro colegio marca su relevancia e importancia en los aportes a la humanidad.
La importancia de la feria de ciencias es que es una herramienta educativa, facilitan el desarrollo de habilidades, mejoran la concepción de fenómenos científicos, facilitan la autonomía y mejoran la autoestima de los alumnos.
Le vendredi 25 août, nous avons célébré la fête de la Science au sein de notre établissement. Les élèves de maternelle, de primaire et de secondaire ont participé à cet événement scientifique. Beaucoup d’entre eux ont démontré leurs compétences et leurs savoirs au travers de projet. Notre Foire de Sciences porte le nom de Louis Pasteur en reconnaissance à ses réussites scientifiques. On connaît notamment la création de la technique de la pasteurisation, pour ses théories sur les microbes, pour le développement de vaccins, d’antibiotiques, de stérilisation et l’hygiène permettant de guérir et de prévenir la propagation des maladies infectieuses. Notre établissement souhaite donc soulever l’importance de ses apports à l’Humanité.
Cette Foire de Sciences représente un outil éducatif, facilitant le développement de compétences, améliorant la conception des phénomènes scientifiques, facilitant l’autonomie et améliorant l’auto-estime des élèves.
Preselección de proyectos Nivel Inicial y Nivel Primario
Pre-selección de proyectos Nivel Secundario
Feria de Ciencias 2023
ODS correspondientes / ODD pertinents
|
¿Qué son los ODS? Los ODS son el núcleo de la Agenda 2030, un programa universal para el desarrollo sostenible elaborado por los Estados Miembros de las Naciones Unidas y adoptado por la ONU, cuya ambición es transformar nuestro mundo erradicando la pobreza y la desigualdad, al tiempo que se garantiza una transición ecológica e integradora de aquí al 2030. |
Que sont les ODD ? Les ODD sont au cœur de l’Agenda 2030, un programme universel pour le développement durable, élaboré par les États membres des Nations Unies et adopté par l’ONU, dont l’ambition est de transformer notre monde en éradiquant la pauvreté et les inégalités, tout en assurant une transition écologique et solidaire à l’horizon 2030. |